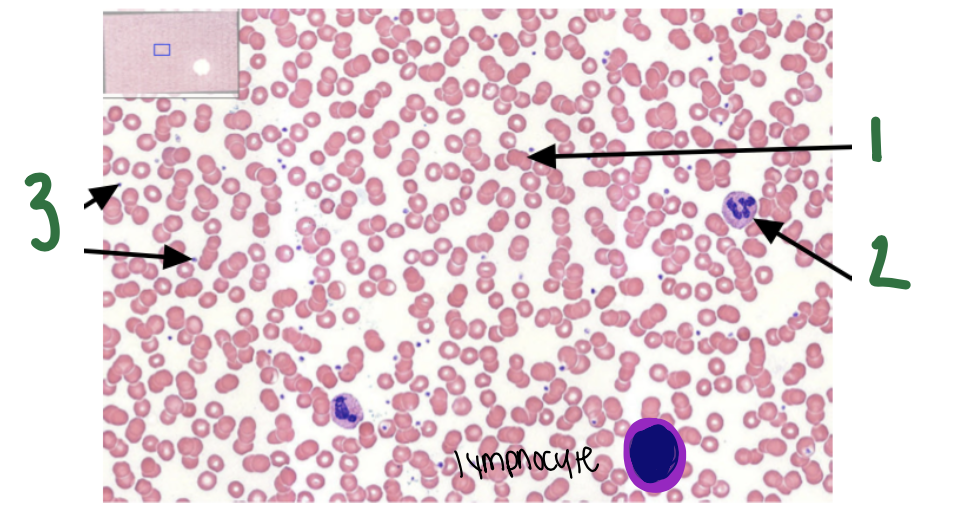

1
Q

A
- simple cuboidal epithelium
- apical surface
- basement membrane
2
Q

A
- stratified cuboidal epithelium
- basement membrane
- apical surface
3
Q

A
- simple squamous epithelium
- basement membrane
- apical surface
4
Q

A
- stratified squamous epithelium (keratinized)
- basement membrane
- apical surface
5
Q

A
- stratified squamous epithelium (non-keratinized)
- basement membrane
- apical surface
6
Q

A
- simple columnar epithelium
- basement membrane
- apical surface
7
Q

A
- stratified columnar epithelium
- apical surface
- basement membrane
8
Q

A
- pseudostratified ciliated columnar
- basement membrane
- apical surface
- cilia
9
Q

A
- transitional epithelium
- apical surface
- basement membrane
10
Q

A
areolar connective tissue
- lymphocyte
- elastin fibers (left)
- collagen (right)
- fibroblast
- macrophage
11
Q

A
adipose connective tissue
- nucleus of adipocyte
- adipocyte
12
Q

A
reticular tissue
(lymph node)
- reticular fibers
13
Q

A
dense regular tissue
(tendon)
- fibroblast nuclei
- fibroblasts
- collagen fibers
14
Q

A
elastic tissue
(aorta)
- dense regular tissue
- elastin fibers
15
Q

A
dense irregular connective tissue
(dermis)
- collagen
- elastin fibers
16
Q
A
fluid connective tissue
(blood)
- erythrocyte
- neutrophil
- platelets
17
Q

A
hyaline cartilage
(trachea)
- collagen matrix
- chondrocyte
18
Q

A
elastic cartilage
(epiglottis)
- chondrocytes
- collagen matrix
19
Q

A
fibrocartilage
(intervertebral disc)
- chondrocytes
- collagen fibers
20
Q

A
bone connective tissue
- osteocyte
- central canal
- osteon
21
Q

A
skeletal/striated muscle tissue
- striations
- nucleus
- skeletal muscle fiber
22
Q

A
cardiac muscle
(ventricle)
- cardiac muscle fiber
- nuclei
- intercalated disc
23
Q

A
smooth muscle
(intestine)
- smooth muscle cell
- nuclei
24
Q

A
nervous tissue
(thoracic spinal cord)
- motor neuron with nuclei


